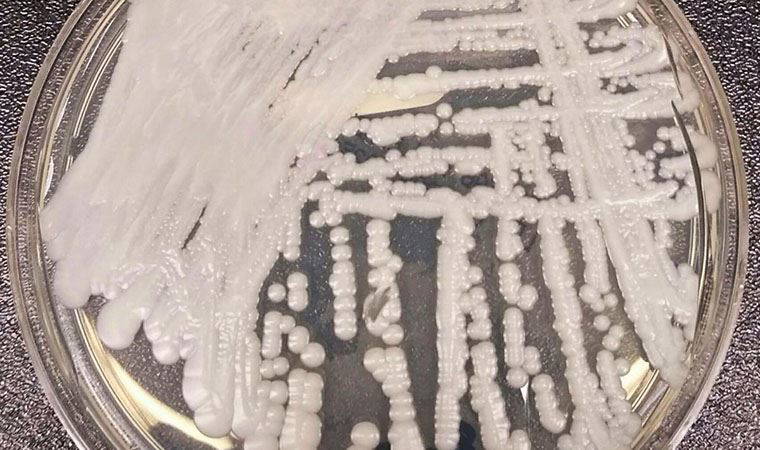
ABD'de ilaçlara karşı dirençli süper mantar yayılıyor

Deutsche Welle Türkçe'nin aktardığına göre, Alman kimya ve ilaç devi Bayer, 2018 yılında satın aldığı Monsanto'nın glifosat içeren, Türkiye'de de satılan Roundup isimli zirai tarım ilacının kansere neden olduğu gerekçesi ile açılan bir davayı daha kaybetti. San Francisco'daki mahkeme, kanser olmalarının nedeninin Roundup ilacı olduğunu savunan çifti haklı bularak şirketi 86 milyon dolar tazminata mahkum etti. Bu, Bayer'in aynı konuya ilişkin kaybettiği üçüncü dava. Şirket, yüksek mahkemeye başvurmayı planlıyor.
Bayer, 2020 yılının Şubat ayında söz konusu davalara ilişkin açıklama yapmış, "davacıların iddialarını destekleyecek bir kanıt olmadığını” söylemişti. Mahkemenin son kararını da anlayamadığını belirten şirket, "Mahkemenin kararını anlayamıyoruz, hiçbir kanıtla ya da hiçbir ilgili kanunla desteklenmiyor” ifadelerini kullandı. Seçenekleri değerlendirdiğini belirtilen şirket, glifosatın güvenliğine sonuna kadar inandıklarını açıkladı. Bayer bilimsel araştrımaların ve yetkili merciler tarafından verilen onayların glifosatın güvenli olduğunu gösterdiğini savunuyor. Ancak yapılan başka araştırmalar, glifosatın kansere yol açabildiğini ortaya koyuyor.
Bayer, 2018 yılında Monsanto’yu 63 milyar dolara satın almasının ardından, glifosat davalarıyla karşılaşmıştı. Bayer, şimdiye kadar yabani otlara karşı kullanılan glifosat maddesinin kansere yol açtığı gerekçesiyle hakkında açılan davalar için oluşturduğu 11 milyar dolarlık bütçeye kısa süre önce 4,5 milyar dolar daha eklemişti.
2019 yılında mahkeme, kanser olan davacılar Alberta ve Alva Pilliod çiftine 2 milyar dolar ödenmesini hükmetmişti. Daha sonra bu miktar 86 milyon dolara indirildi.